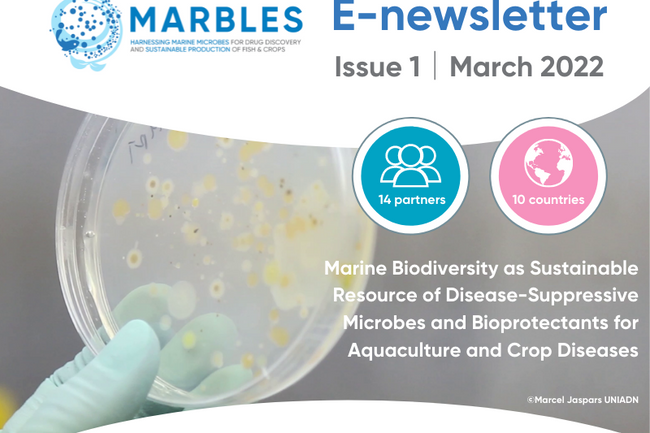
image-bed39ce3139347c511bec31761eabc5ffdd00682-800x600-png

News
Filter News by:
news

Awaken sleeping antibiotics with ERC Advanced Grant
01 Jun 2022
Our MARBLES coordinator Gilles van Wezel was recently awarded a European Research Council Advanced Grant of €2.5 million for a new research project called COMMUNITY.
news

Microbes key to stopping the next pandemic
30 May 2022
Preventing future pandemics depends on better understanding of the billions of microbes circulating all around us in nature
news

Launch of the AIMS Cluster
25 May 2022
MARBLES forms cluster with fellow projects Algae4IBD, InnCoCells and SECRETed (AIMS) funded under the Call ‘FNR-11-2020: Prospecting aquatics and terrestrial natural biological resources for biologically active compounds.’
news

Study suggests dolphins use corals and sponges to treat their skin conditions
24 May 2022
The dolphins rub their body parts against specific corals and sponges, the study suggests the mucus the corals & sponges release, plays a role in regulating the dolphin’s skin microbiome and therefore treats skin infections
news

Organic pesticides to provide natural protection for endangered crops
02 May 2022
Scientists from the BIOBESTicide project are trying to find a biological solution
news

Kelp blades host dense microbial biofilms
15 Apr 2022
Kelp, a type of seaweed is colonised by complex microbial communities
news
The first MARBLES E-Newsletter is out now!
11 Mar 2022
MARBLES E-Newsletter Issue 1 has been published, you can read it here!
news

Start-up raises £50M funding to develop technology which uses the body’s microbiome to discover and develop medicines
07 Mar 2022
The human body’s gut microbiome controls our health, disease and drug responses
news

MARBLES in the Leiden EU City of Science 2022
17 Feb 2022
The EU City of Science is a festival dedicated to people of all ages who are curious about science and technology. It is one of the largest public engagements in science and technology events in Europe.
news

Diving into the abyss for new medicines
15 Feb 2022
The potential for new pharmaceuticals lies in the ocean, but its biodiversity is unprotected and under threat.
news

Marine sponge sampling in Trondheim Fjord by MARBLES partner SINTEF
26 Jan 2022
Sponges were collected from the vast Lophelia coral reef
news

Biopharmaceutical company raises $61 million to advance novel small-molecule medicines mined from microbial genomes
14 Dec 2021
Hexagon Bio, a biopharmaceutical company pioneering the discovery of medicines encoded in the global metagenome has raised $61 million to fuel the continued development of its platform to design and develop new therapeutics mined from microbial genomes.